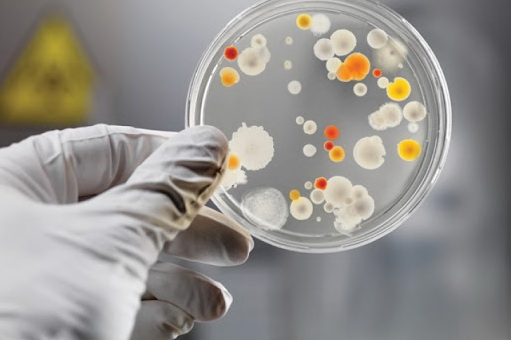
Сказ, малярія, лептоспіроз: епідеміологічна ситуація в області

За неделю на Днепропетровщине зарегистрировано более 320 случаев не респираторных инфекционных болезней.
Вчера мы сообщали, что на Днепропетровщине впервые обнаружили новый подвариант COVID-19 - Omicron Nimbus у женщины из Днепра. Основной симптом - острая боль в горле. Всего за прошедшую неделю в регионе COVID-19 заболели 1164 человека.
Также неделю на Днепропетровщине зарегистрировано более 320 случаев других инфекционных болезней.
Так, в Днепре зафиксировали подозрение на малярию у женщины, которая вернулась из Южного Судана.
По экстренным сообщениям из учреждений здравоохранения, по состоянию на 1 сентября медики зафиксировали инфекционные заболевания у 30 человек. Еще у 18 человек - подозрение на острые кишечные инфекции. В Днепре подозревают лептоспироз у 52-летнего мужчины, который занимался рыбалкой.
Также в области выявлено бешенство среди животных. После контакта с больным животным к медикам обратились девять человек, среди них один ребенок.
![]() |
Gorod`ской дозор |
![]() |
Фоторепортажи и галереи |
![]() |
Видео |
![]() |
Интервью |
![]() |
Блоги |
| Новости компаний | |
| Сообщить новость! | |
![]() |
Погода |
| Архив новостей | |